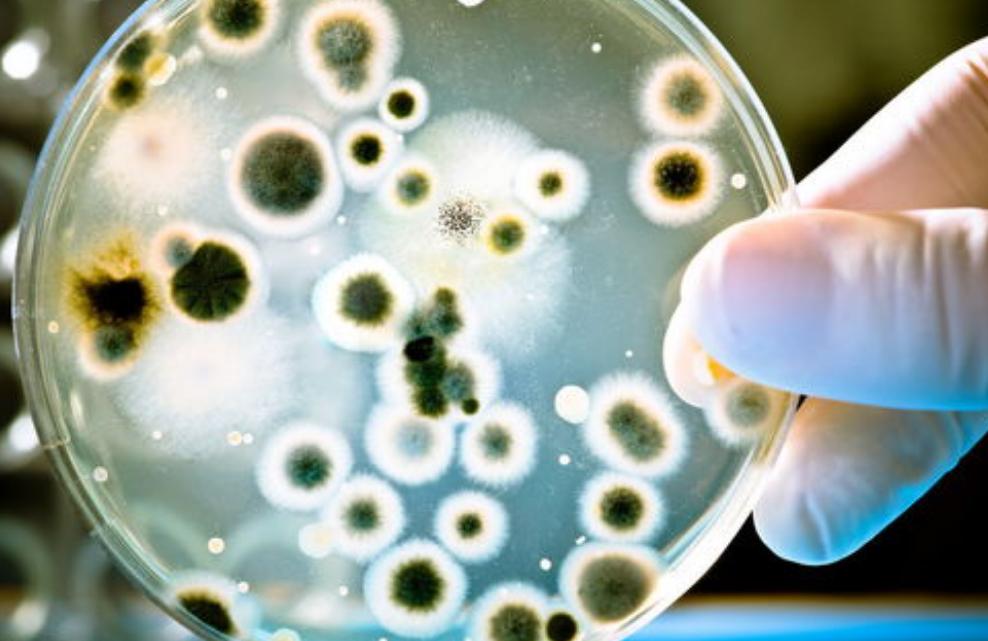
女人平时需要警惕的表现,女性身上有异味是大病的前兆

小贾今年已经28岁了,和男朋友已经在一起5年了,两人几乎从来都没有发生过争吵。现在两人的工作也逐渐稳定了,两个人便在父母的见证下将婚期定在了十一国庆节。
想着很快就要结婚了,两人便搬到了一起住,小贾男朋友也顺势提出来想要关系更进一步。为了第一次,两人都各怀心思,在网上搜索各种资料,以防到时候发生尴尬的事情。
在网上,小贾看到很多男性第一次都会特别在意女性*处私**的味道,这让她也注意起来这件自己从来没有专门关注过的事情,她发现自己的*处私**竟然散发出来一股“酸奶”的味道,还伴有一丝丝的腥味。

为了避免尴尬,小贾专门买了带有香味的沐浴露进行全身清洗,但是也只能短暂地掩盖原本的气味,她实在担心这件事情会影响到给未婚夫的第一次印象,便一个人偷偷去到了医院咨询。
一、女性*处私**有酸奶味正常吗?为什么会有这种味道呢?
经过医生耐心的讲解,小贾才把悬着的心放下,原来人类身体的不同部位会散发出不同的味道,每个人散发出来的味道也会有所不同。那么,女性的*处私**为什么会有酸奶味呢?
有数据表明,在健康状态下,女性的生殖系统含有20~30种不同的菌群,其中有乳酸杆菌、双歧杆菌、加德纳菌等等。这些菌群之间相互制衡可以使阴道环境处于一种生态平衡的状态,有利于防止其他病毒的入侵,保护阴道健康。

有研究指出,在这些菌群中,乳酸杆菌是一种优势菌群,占阴道菌群的70~95%。乳酸杆菌可以使糖类发酵,进而产生乳酸或者酸性物质;
同时具有较强的代谢碳水化合物产酸的能力,这种功能可以使女性*处私**的PH值维持在4.5左右,一种弱酸性的环境,这种环境不但有利于女性阴道微生态的平衡还会发出一种“酸奶味”。

因此,小贾的*处私**发出酸奶味,并伴有轻微的腥味是一种正常的现象。那么阴道正常的味道都有哪些呢?又有哪些异常情况需要警惕的呢?
二、阴道出现这三种气味,一定要警惕了!
除了前文提到的酸奶味,女性的阴道会因为多方面因素的影响而散发出不同的味道,比如:汗味,为了调节体温,人体的汗腺会排出汗液;
尤其是对于青春期的女性而言,机体的新陈代谢会明显加快,出汗的情况也会比较多,再加上阴道处通风效果较差,就容易发出汗味;
铁锈味,女性在月经期间会排出经血,其中虽然掺杂着阴道分泌物,但是经血的血腥味会将阴道本身的酸味盖住,再加上其中含有大量的红细胞,红细胞里有含有血红蛋白,血红蛋白中携带大量的铁离子,因此,在月经期女性的阴道也会散发出一股铁锈味。

这两种气味都属于正常的情况,除此以外,如果近期食用了含有特殊成分的食物,经过机体的代谢分解就会导致短暂的异味。比如常被用作调味品的孜然和咖喱,虽然可以让食物更加有味道,但是其气味挥发的比较慢,甚至可以在体内滞留好几天。
有研究表明,如果孕妇在怀孕期间常食用含有强烈气味的咖喱、孜然等食物,有可能会影响到胎儿的体味。
这些气味和“异味”都属于正常的生理现象,不需要过于担心,但是一旦阴道发出以下几种气味,一定要引起重视:
1.金属味
前面提到,女性的阴道在月经期会因为经血中的血红蛋白含有大量的铁离子,而散发出一种铁锈味,也可以理解为金属味,是一种正常生理的现象。
但是,如果在非经期出现不规则的阴道出血,其中也会含有大量的铁离子,因此而发出金属味,此时就要注意是否是慢性宫颈炎导致子宫颈充血、变薄,此时很容易发生接触性出血或者宫颈外口破溃出血。
2.腥臭味
由于女性阴道菌群中本身含有加德纳菌和厌氧菌,这些菌群会使女性的*处私**散发轻微的腥味,这是一种正常的生理现象,在衣服的隔绝下,通常很难闻到。但是当阴道的生态平衡被破坏之后,这些菌群就会异常增殖,就有可能加重这种腥味,在日常生活中便可以闻到。

比如:因阴道菌群失衡导致厌氧菌大量增殖的,进而引发细菌性阴道炎;这些厌氧菌在增殖的过程中会释放三甲胺等胺类物质,释放出来浓郁的腥臭味。
3.恶臭味
女性的*处私**散发出来恶臭味通常是由于存在宫颈病变,因为宫颈病变会导致皮肤黏膜充血、变薄,甚至是破溃,易导致接触性出血或者感染,出现血性或者脓性白带,就会散发出一种恶臭味。
此外,如果阴道内有异物,像被遗忘的卫生棉条,在阴道潮湿的环境中,也可能会导致皮肤腐烂,发出恶臭。

不过,是否是阴道疾病也要结合其他症状进行判断,比如:阴道奇痒难耐、阴道疼痛、白带增多、出现泡沫样白带、豆腐渣样白带、血性或者脓性白带,很可能在提示细菌性阴道炎、霉菌性阴道炎、宫颈炎等疾病。
因此,女性要注意关注自己*处私**的气味,及早地发现自己身体的异常情况并遵医嘱进行抗炎等治疗,以防引发宫颈癌等不良后果。
那么,在日常生活中,女性该如何让保护自己的阴道呢?
三、上了年纪,该如何避免*处私**异味呢?
女性的阴道是一个相对开放的环境,容易受到外界细菌及病毒的侵袭,因此,从小事做起保护阴道健康是非常重要的。
首先要保持阴道的清洁、干燥。女性的阴道会在激素的作用下产生分泌物,如果不及时清洗很容易造成细菌感染。因此,可以在每天晚上睡前进行阴道清洗。

清洗的时候尽量选淋浴清洗的方式,因为流动的温水可以减少细菌残留以及逆行感染。清洗时要注意清洗的顺序,从前(阴道)往后(肛门)进行清洗,以防将肛门处的细菌带至阴道,增加感染的风险。
此外,清洗时要尽量避免使用碱性清洗剂,否则容易打破阴道弱酸性的环境,导致细菌过度繁殖,引发阴道炎等妇科疾病。清洗的手法也要特别注意,要避免水流直冲阴道,要使其从外阴部位的侧边慢慢流过;
清洗之后,用专用毛巾及时擦干,待阴道处完全干燥之后再更换干净的*裤内**,以防潮湿的环境给细菌提供滋生的机会;在清洗及擦干的过程中,要保持手法轻柔,避免过度摩擦导致皮肤破损、感染。

如果处于月经期或者是*行为性**前后可以适当增加阴道清洗的次数,但是要杜绝穿着*裤内**直接洗澡,很容易导致细菌或者清洗液进入阴道,引发炎症。
除此之外,*裤内**的正确清洗也是非常重要的。在清洗*裤内**时,要尽量用流动的温水加清洗液手洗,这样可以使清洗液中的酶起到更好的清洁作用,整体清洗之后要重点清洗裤裆部,尽量减少细菌的残留。
清洗干净之后,要将*裤内**放在通风处进行晾晒,也可以放在阳光下晾晒,起到一定的杀菌作用;如果是患有阴道炎等疾病的患者需要更好的杀菌效果可以选择用开水煮,但是也要注意频率。

同时在*裤内**的选择上也不能有所松懈,要尽量选择纯棉、浅色且没有图案的宽松且合身的*裤内**,以防*裤内**掉色或者过紧,增加阴道与*裤内**的摩擦,提高感染的风险。
总结:
女性*处私**散发出“酸奶味”,是一种正常的生理现象,不必过度担心或者过度清洁,也没有必要使用香水去可以掩盖。此外,因为机体新陈代谢以及运动等,女性的阴道也会发出金属味或者汗味,如果没有阴道瘙痒等症状,注意清洗就可以。
不过当阴道散发出明显的异味时一定要引起重视,及时到医院进行白带常规及妇科彩超等检查,尽早地发现疾病并治疗。
参考文献:
[1]李凡娥. 中医可通过白带测女性健康[N]. 大众健康报,2022-07-20(015).DOI:10.28213/n.cnki.ndzjk.2022.000639.
[2]张萧萧.*处私**有异味,留心妇科病[J].人人健康,2021(13):53.
[3]章蓉娅.*处私**为何总有异味?[J].健康之家,2013(12):80.